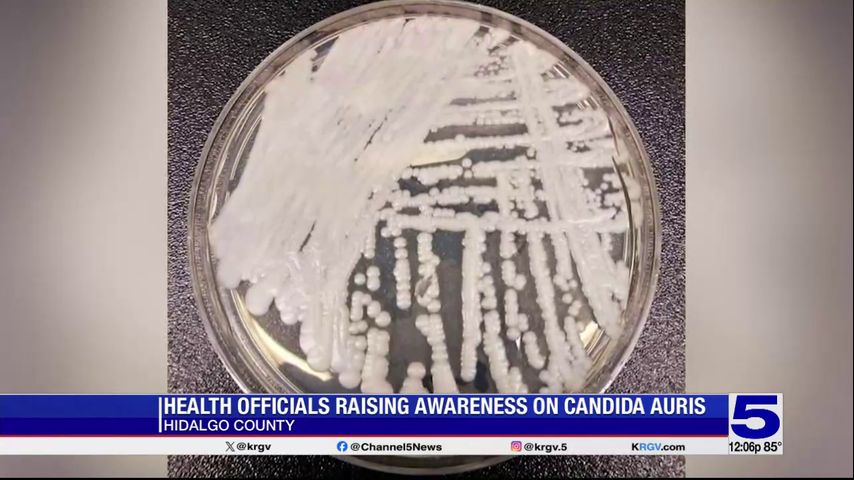
Featured image for Valley Health Monitors Deadly Fungal Infection Cases

Candida auris: The Global Superbug Spreading in US Hospitals
Tennessee reported 189 cases of the drug-resistant fungus Candida auris in 2025, part of a nationwide increase in infections that pose a serious threat to vulnerable patients in healthcare settings due to its resistance to multiple antifungal drugs and ability to spread on surfaces and equipment.